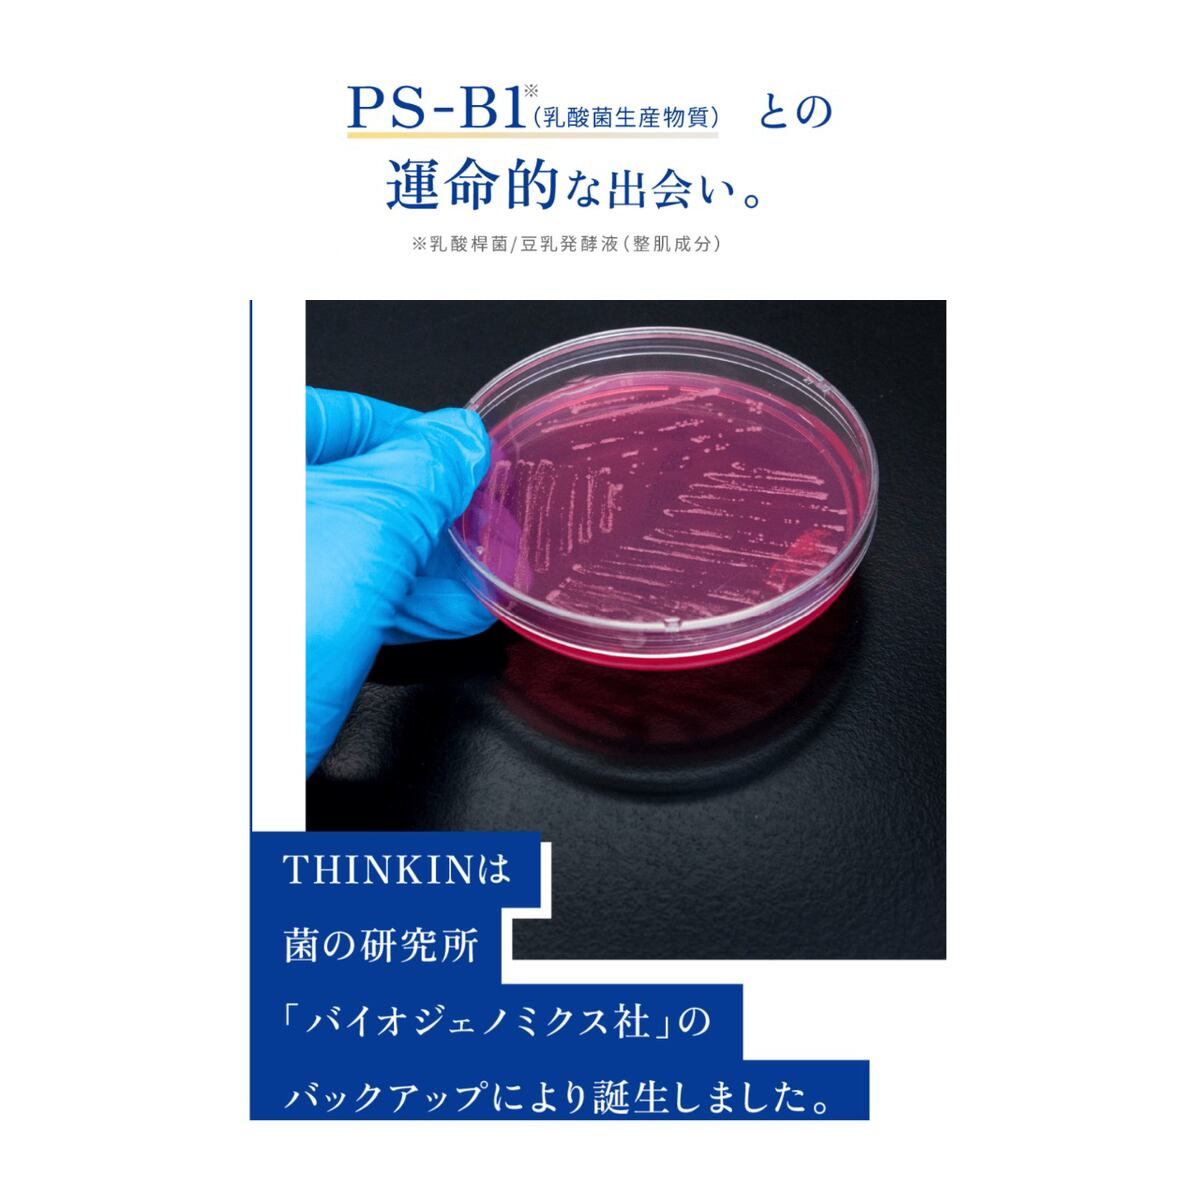

- NEW ARRIVALS
-
CATEGORY
- ABOUT
- BLOG
- CONTACT
定期便【THINKIN】ウィークリークレンザー|角質ケア・毛穴スッキリ・週1回のスペシャル洗顔(60g)
\週に1度のご褒美洗顔/
肌に不要な角質や毛穴汚れをやさしくオフし、スキンケアの入りを良くする“酵素入り”のスペシャルクレンザー。
THINKIN(シンキン)ウィークリークレンザーは、肌に必要なうるおいを守りながら、古い角質や毛穴の詰まりをしっかり洗浄。乳酸菌由来成分「PS-B1」が肌をすこやかに整え、つるんとした透明感のある肌へ導きます。
特徴
✨ 週1回の集中ケア
毎日使わず週1回でOK。摩擦レスな泡で肌負担も少なく、やさしく角質オフ。
✨ 酵素洗顔+乳酸菌(PS-B1)
酵素成分が古い角質や毛穴汚れをしっかり分解。さらに乳酸菌生産物質「PS-B1」が肌のバリア機能をサポート。
✨ 泡立たないペーストタイプ
肌になじませるだけで不要な角質や皮脂を浮かせて落とす、泡立て不要の時短処方。
✨ 肌にやさしい処方
アルコール・合成香料・着色料不使用で、敏感肌の方も安心。
◎使用方法
顔を濡らさず、乾いた肌に適量(さくらんぼ粒大)を手に取ります。
顔全体にやさしくなじませ、30秒〜1分ほど置きます。
ぬるま湯でしっかり洗い流してください。
※週に1〜2回の使用がおすすめです。
内容量・価格
・60g
・税込価格:9,310円 定期便価格
こんな方におすすめ
✔ 毛穴の黒ずみ・詰まりが気になる方
✔ ごわつき・くすみをケアしたい方
✔ スキンケアの入りを良くしたい方
✔ 敏感肌でも使える角質ケアを探している方
配送について
・ご注文後、2〜3営業日以内に発送いたします。
・送料:全国一律送料無料
※この商品は定期便です。毎月1回のお届け予定です。
※価格は1回分の価格になります。